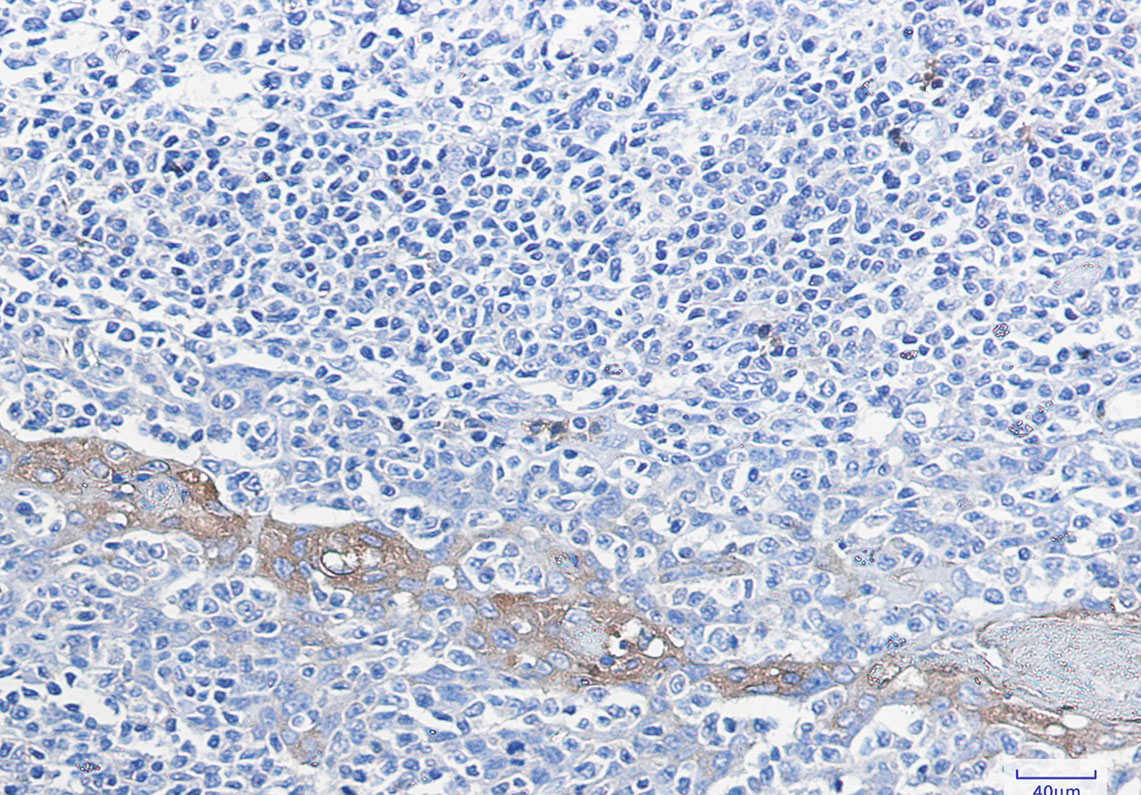

-
分类: 科研抗体货号: P21434别名: GCN5; hGCN5; GCN5L2; PCAF-b应用: WB,IP反应种属: Human
-
分类: 科研抗体货号: P21462别名: Gnb2; Gnb2l1; RACK1; Transducin beta chain 2应用: WB,IP,IF反应种属: Human,Mouse,Rat
-
分类: 科研抗体货号: P21448别名: G6PD; Glucose-6-phosphate 1-dehydrogenase; G6PD应用: WB,IP,IHC反应种属: Human,Rat
-
分类: 科研抗体货号: P21461别名: GAQ; SWS; CMC1; G-ALPHA-q应用: WB,IP,IHC反应种属: Human,Rat
-
分类: 科研抗体货号: P21466别名: GPCR; Lgr6应用: WB,IHC,IF反应种属: Human,Mouse,Rat
-
分类: 科研抗体货号: P21447别名: GR; GCR; GRL; GCCR; GCRST应用: WB,IF反应种属: Human,Mouse,Rat
-
分类: 科研抗体货号: P21459别名: NET1; GLYT2; HKPX3; GLYT-2应用: WB反应种属: Human,Rat
-
分类: 科研抗体货号: P21465别名: GPR37; Probable G-protein coupled receptor 37; Endothelin B receptor-like protein 1; ETBR-LP-1; Parkin-associated endothelin receptor-like receptor; PAELR应用: WB反应种属: Rat
-
分类: 科研抗体货号: P21477别名: GBP; ECHA; HADH; LCEH; MTPA; LCHAD; TP-ALPHA应用: WB,IP,IHC,IF反应种属: Human,Mouse,Rat
-
分类: 科研抗体货号: P21457别名: GYS1; GYS; Glycogen [starch] synthase; muscle应用: WB,IP,IHC,IF反应种属: Human

鄂公网安备42018502007531号
鄂公网安备42018502007531号

